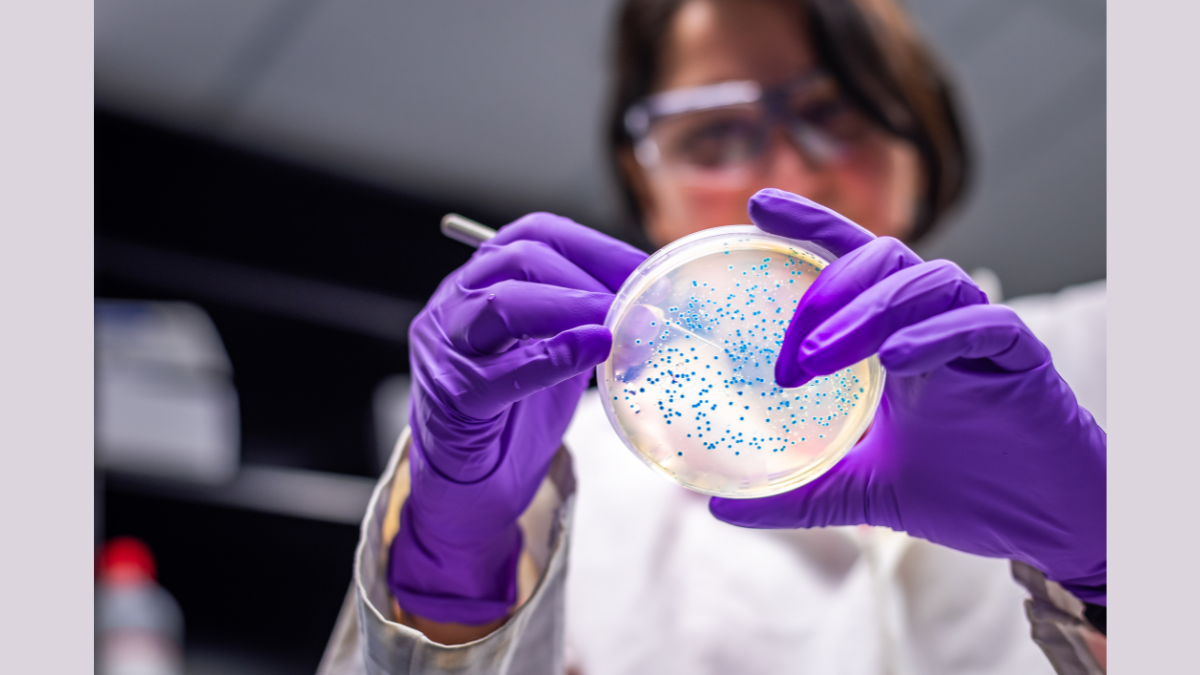

Environmental antibiotic resistance unevenly addressed despite growing global risk, study finds
Antibiotic resistance in the environment is a growing and largely overlooked crisis receiving inconsistent attention, that may very well have dire consequences for human health, according to a new study led by the University of Surrey.
The comprehensive review, published in Environment International, researched 13,000 studies from 1990 to 2021 to identify patterns and gaps in the topic area. The team identified 738 studies that focused strictly on non-built, non-industrial environments, such as rivers, fields and air.
The researchers found that antibiotic-resistant bacteria are most often detected in freshwater and soil, particularly in places exposed to pollution from wastewater or manure. Two bacteria - Escherichia coli and Pseudomonas - were the most studied organisms, while genes conferring resistance to medicines including sulphonamides, tetracyclines and beta-lactams, were very prominent.
Worryingly, very few studies have explored how antibiotic resistance spreads in the air, oceans or green spaces. The team also highlighted a lack of research in low-income regions, where the health burden of antibiotic resistance is likely to be highest.
The Surrey team also found that a third of the studies came from China, followed by the United States. But fewer than one percent were led by researchers in low-income countries, such as Afghanistan, Ethiopia, Mali and Uganda, despite these areas facing some of the greatest health risks from antibiotic resistance. Climate change and microplastics were also strikingly absent from the evidence base. While this trend may have shifted in last couple of years, given the rapid evolution of the field, it is unlikely to have changed substantially, leaving critical questions unanswered about how environmental shifts may be accelerating the problem.
Related sustainable development goals
Featured Academics
Media Contacts
External Communications and PR team
Phone: +44 (0)1483 684380 / 688914 / 684378
Email: mediarelations@surrey.ac.uk
Out of hours: +44 (0)7773 479911
